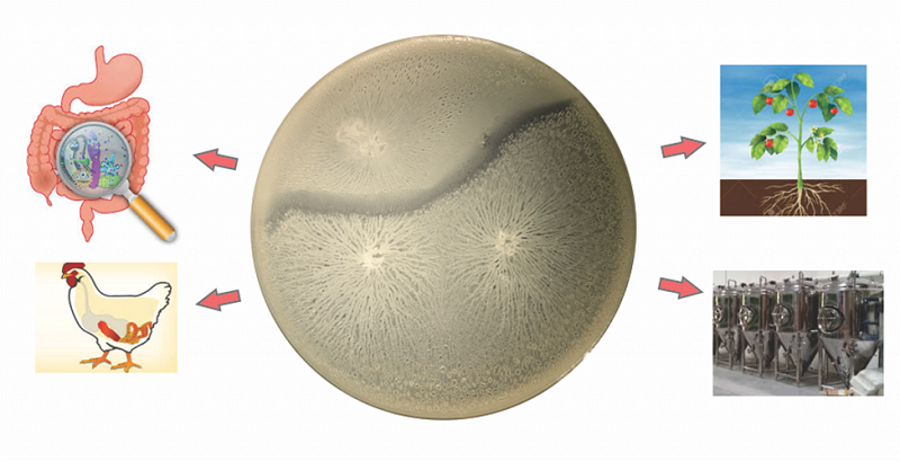

Na Katedri za mikrobiologijo nas družuje zanimanje z fiziologijo bakterij in molekularnimi mehanizmi, ki vplivajo na bakterijske interakcije. Z izkoriščanjem pestrosti naših raziskovalnih ozadij, klasične mikrobiološke metode lahko dopolnjujemo z molekularno mikrobiologijo, mikroskopijo na nivoju posamnih celic in 3D, kvantitativno analizo slik, biokemijo, biofiziko, matematičnim modeliranjem ali primerjalno genomiko.
Preučujemo mikrobne ekosisteme na več ravneh organizacije, od posameznih celic in njihovih odzivov na lokalno okolje, do interakcij med celicami znotraj klonskih populacij (Sretanovic et al., 2017 PMID: 28790301; Spacapan et al., 2018; Dogsa et al. , 2021), interakcij med različnimi sevi iste vrste (Oslizlo et al., 2015; Stefanic et al., 2015; Lyons et al., 2016; Stefanic et al., 2021; Kreigher et al., 2021), kot tudi v večvrstnih skupnostih, kjer so "dobre" bakterije soočajo z patogenimi sevi (Erega et al., 2021). Sprašujemo se tudi, kako lahko fagi oblikujejo fiziologijo ali ekologijo bakterij (Dragos et al., 2020; Dragos et al., 2021).
Delamo z mikrobi biotehnološkega pomena, kot sta Bacillus subtilis, Campylobacter jejuni, ali Salmonella enterica serovar Typhimurium v okviru ekološko pomembnih eksperimentalnih modelov, na primer kompleksnih celičnih agregatov, imenovanih biofilmi. Poskušamo razumeti pričetek tvorbe biofilma, kadar se celice pritrjujejo na površine, nadzor rasti in razvoja biofilma ter časovne spremembe njegovih viskoelastičnih lastnosti (Horvat et al., 2019; Spacapan et al., 2019; Simunič et al., 2020; Terlep et al., 2021). Vzpostavili smo tudi modelni sistem za preučevanje bakterijskega samoprepoznavanja tekom rojenja na mehnim agarju, proces, poznan kot sorodstveno prepoznavanje (Stefanic et al., 2015; Lyons et al., 2016). Poleg molekularnih mehanizmov v ozadju tega procesa nas zanima, kako sorodstveno prepoznavanje vpliva na vedenje v heterogenih skupinah, posebno ločevanje genotipov, horizontalne prenose genov ali proizvodnjo in delitev izločenih molekul (encimov, polisaharidov ali toksinov/antibiotikov) (Stefanic et al., 2021; Kreigher et al., 2021).
Medtem ko nas motivirajo temeljna znanstvena vprašanja, aktivno iščemo aplikacije za svoje raziskave na različnih področjih biotehnologije, npr. živilska industrija (patent), tehnologija odpadnih voda (Kreigher & Mandic-Mulec, 2020) ali biomedicina.
Slika 1: Sorodstveno prepoznavanje pri Bacillus subtilis in potencijalne aplikacije.

Slika 2: Desno: Kokultura dveh fluorescenčno označenih sevov B. subtilis je bila nacepljena v tekoče gojišče. Pelikel, ki nastane po 16 urah, kaže ločitev obeh sevov v vijolične in modre skupine. Na levi: mikropretočni sistem, zasnovan za zajemanje rastočih celic B. subtilis. Podolgovate bakterijske verige so zasedle razpoložljivi prostor.

Slika 3: Interakcije med bakterijama B. subtilis (rdeča) in Salmonella enterica serovar Typhimurium (zelena) na trdnem gojišču TSB. Na sliki so prikazane interakcije po 48 h ur gojenja, kjer vidimo invazijo bakterije B. subtilis v kolonijo bakterije S. Typhimurium – predvidevamo, da bakterija B. subtilis sintetizira protimikrobne spojine, ki povzročijo lizo celic bakterije S. Typhimurium.
